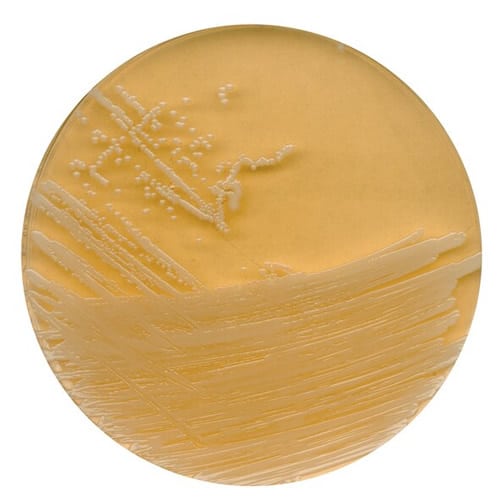

- A Empresa
- Produtos
Categorias
Tudo para laboratórios.
Grandes marcas
As marcas lideres de mercado
Segmentos
Tudo para o seu segmento
Alpax
Qualidade, Inovação e Transparência
Em mais de 30 anos de mercado nos tornamos referência em distribuição de produtos e equipamentos para laboratórios, sempre inovando com qualidade e transparência à serviço da satisfação do cliente.
- Serviços
- Blog
- Downloads
- Contato
- A Empresa
- Produtos
Categorias
Tudo para laboratórios.
Grandes marcas
As marcas lideres de mercado
Segmentos
Tudo para o seu segmento
Alpax
Qualidade, Inovação e Transparência
Em mais de 30 anos de mercado nos tornamos referência em distribuição de produtos e equipamentos para laboratórios, sempre inovando com qualidade e transparência à serviço da satisfação do cliente.
- Serviços
- Blog
- Downloads
- Contato